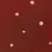

Prodotti all'ingrosso di Finding Farmhouse Crafts & More
Prodotti all'ingrosso di Finding Farmhouse Crafts & More
Prodotti all'ingrosso di Finding Farmhouse Crafts & More
Trova prodotti per il tuo negozio nei cataloghi di migliaia di brand.
Accedi ai prezzi all'ingrossoInformazioni su Finding Farmhouse Crafts & More
Benvenuti! Siamo un'azienda artigianale a conduzione familiare, madre e figlia, situata nella selvaggia e meravigliosa Virginia Occidentale. Abbiamo iniziato a vendere alle fiere artigianali oltre 10 anni fa. L'artigianato è la nostra passione e ci impegniamo a soddisfare ogni richiesta e rispondere a qualsiasi domanda il più rapidamente possibile. Spero che apprezziate gli articoli che abbiamo da offrire. Dio vi benedica!